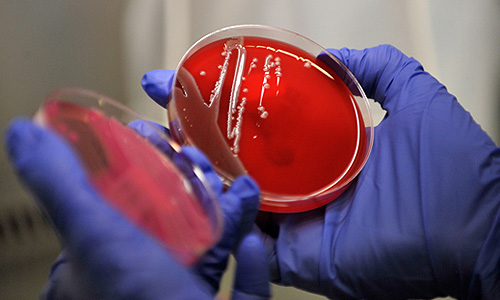

Фотогалереи →
10 июня 2011 года
Россия снимет запрет на поставку овощей из стан ЕС после предоставления гарантий безопасности от Еврокомиссии
На саммите Россия-ЕС достигнута договоренность о том, что Россия отменит запрет на поставку овощей из Европы после того, как получит гарантии безопасности продуктов не на национальных уровнях, а непосредственно от Еврокомиссии, заявил глава Роспотребнадзора Геннадий Онищенко.
Поделиться:
Число погибших от заражения кишечной палочкой E.coli в Германии достигло 14 человек, сообщает во вторник британская телерадиокорпорация ВВС. По мнению специалистов, в ближайшие дни ситуация может ухудшиться, поскольку источник заражения по-прежнему не выявлен.
Фотогалереи

10Фотохроника 2 марта

11Военная операция США и Израиля в Иране

10Фотохроника 27 февраля

10Лучшие фото недели

10Фотохроника 26 февраля

12World Nature Photography Awards

10Фотохроника 25 февраля

10Фотохроника 24 февраля

10Фотохроника 20 февраля

10Лучшие фото недели

10Фотохроника 19 февраля

10Фотохроника 18 февраля

12Олимпиада-2026 в Италии

10Фотохроника 17 февраля

12Празднование Нового года по лунному календарю

10Фотохроника 16 февраля

11Карнавал в Рио-Де-Жанейро

ФотоПарад собак на карнавале в Рио-де-Жанейро

10Фотохроника 13 февраля

10Лучшие фото недели

10Фотохроника 12 февраля
